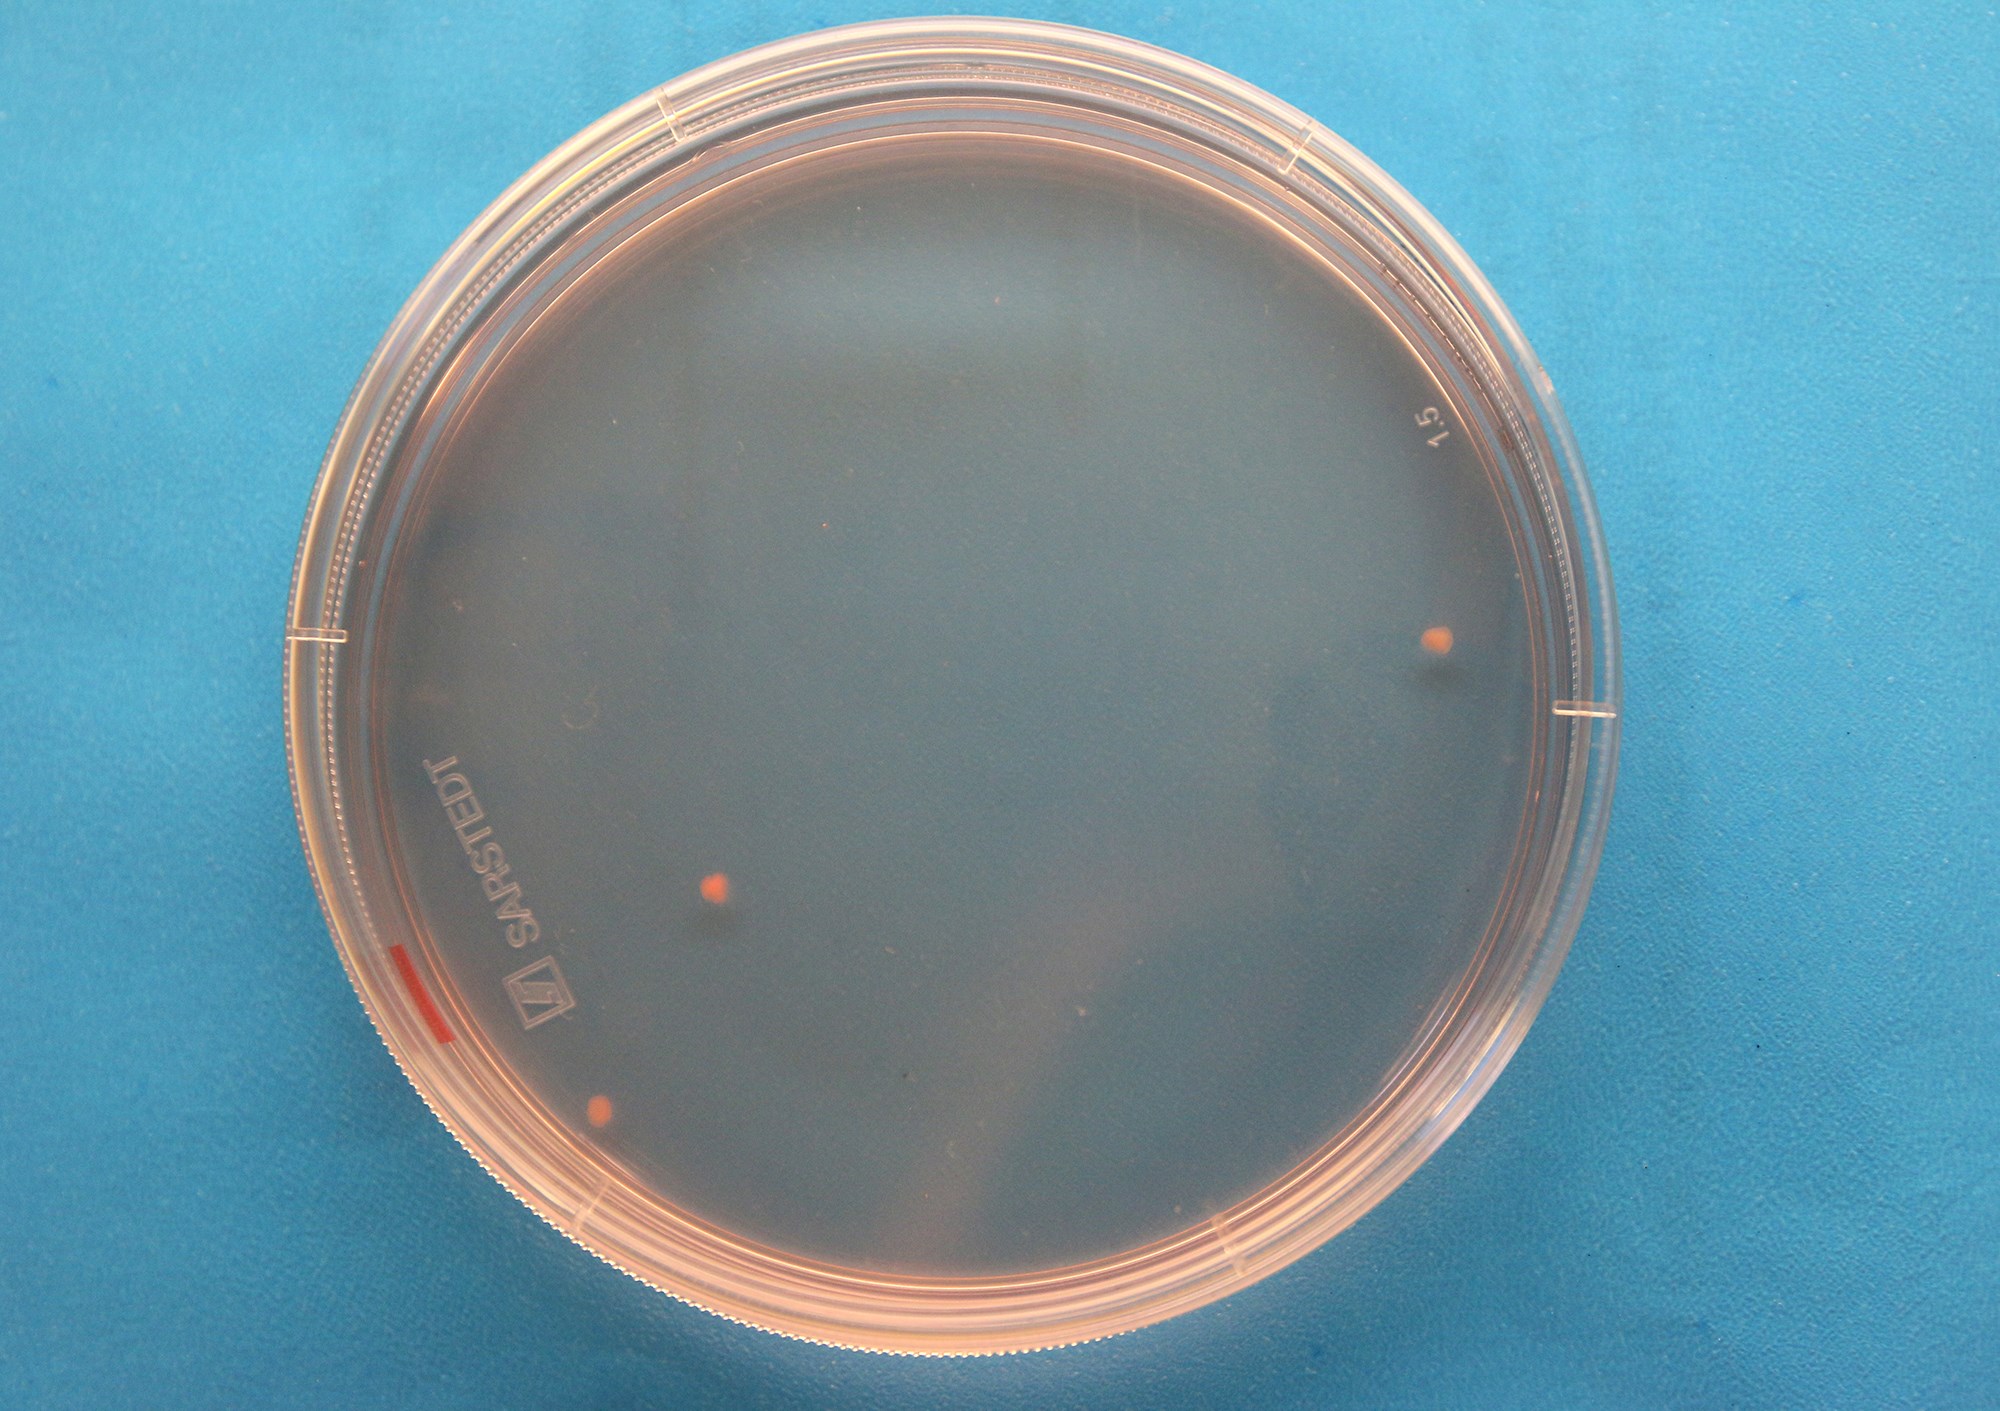
Miniorganer gir håp om behandling av sykdommer

Denne roboten trener seg opp i en virtuell verden – det har gitt den helt spesielle egenskaper
Nå klarer roboten å gripe objekter som ingen andre roboter har klart å gripe før. – En skikkelig “Matrix-robot”, sier forsker Ekrem Misimi.

Nå klarer roboten å gripe objekter som ingen andre roboter har klart å gripe før. – En skikkelig “Matrix-robot”, sier forsker Ekrem Misimi.

Har du peiling på Biologisk mangfold, eller kanskje Deep fakes? Vi har laget quiz igjen. Klarer du ti av ti?

Den norskutviklede kula finner mer plass i kraftlinja. Det gjør også at nettselskapene kan slippe å bygge nye, dyre og omstridte kraftlinjer.

Blågrønne tak, det vil si ekstensive grønne tak som har ekstra underlag for å øke forbruket og forlenge forsinkelsen av overvann, kan gi et viktig bidrag til overvannshåndteringen i urbane områder.

Helsetjenesteforskere i SINTEF har fått i oppdrag å evaluere gjennomføringen av regjeringens opptrappingsplan for psykisk helse, som skal implementeres i årene 2023-2033.

Siden år 2000 har det dødd en fisker på jobb annenhver måned. For å redde livene til fremtidas fiskere må vi omsette kunnskap til handling. Hvordan?

Valg av riktige materialer gjennom hele verdikjeden for hydrogen – fra produksjon til transport, lagring og sluttbruk – er avgjørende for sikker og effektiv bruk av hydrogen og ammoniakk.

En boks på størrelse med et kjøleskap som forsyner huset – og gjerne ti nabohus – med strøm. Det er drømmen til Ole Martin Løvvik i SINTEF.

Ville du betalt én prosent ekstra for en klimavennlig øl eller avokado? Hva med to prosent ekstra i bompenger for en bro der 70 prosent av utslippene er kuttet?

Trapperomsdører i eldre bygårder kan oppgraderes når estetiske hensyn og antikvarisk verdi gjør det ønskelig å beholde eksisterende dørblad.

Etter 15 år som forskningssjef i SINTEF Energi går Knut Samdal videre til en ny og strategisk viktig rolle ved SINTEFs Brusselkontor.

Brannkonstabler driver hardt fysisk arbeid samtidig som de utsettes for stor varmepåkjenning. Nå vet vi mer om hva som skjer med temperaturen i kroppen under en røykdykkerinnsats.

For å nå klimamålene trenger vi å bygge mer strømnett, men vi er også nødt til å utnytte det strømnettet vi allerede har i dag på en bedre måte.

Sammen med ukrainske aktører planlegger SINTEF et pilotprosjekt knyttet til full utnyttelse av byggavfall fra krigsherjingene i Ukraina.

Om vi tilpasser nasjonale verktøy til EUs rammeverk Level(s), blir det enklere å sammenlikne prosjektalternativer og være klar for eventuelle nye EU-krav.

Tauverk og redskaper som brukes i fiskeri og oppdrett er en stor kilde til mikroplast i havet og forsøpling av kystlinjen. Et tverrfaglig og internasjonalt forskerteam har en plan som må gjøres for å redusere forurensingen.

SINTEF Energi var tidlig ute med neste års sommerjobber, og interessen var rekordstor. Hele 369 studenter har søkt på 37 jobber. Det er over 120 flere enn i fjor.

Hvor klimavennlig er byutviklingen i din kommune? Et nytt verktøy hjelper planleggere med å sammenlikne alternativer.

Å oppdage små hull i nettene til merder i sanntid, er ikke en teknologi som er enkelt tilgjengelig i dagens marked. Inspeksjonsfirmaet Njord Aqua og SINTEF har utviklet en programvare som gjør nettopp dette, og dermed kan bidra til å redusere faren...

Havgående skip blir ikke utslippsfrie over natta. En klok start vil være å seile fornybart når det går an, og ikke-fornybart på andre turer, slik et unikt norsk supplyskip snart blir i stand til.

Det er ingen overraskelse at det koster mer å bygge et nabolag som reduserer klimagassutslipp sammenlignet med dagens standard. Men det kan også gi besparelser som faktisk gjør det økonomisk lønnsomt.

SINTEF tester ulike veggvarianter i laboratoriet, og rehabiliterer du et gammelt trehus, kan det hende du kan hjelpe forskerne.

Når du hører at 60 solparker tilsvarer over 5000 fotballbaner, slik NRK nylig har fortalt, er det lett å bli mot solparker. Det er å trekke oppmerksomheten bort fra andre viktige deler av debatten.

Norsk samarbeid om kvanteteknologi blir fornyet i fire år. Det ble klart i dag, da tildelingen av Gemini-senter til SINTEF, NTNU og UiO ble gjort kjent.

Når det brenner, gjelder det å komme seg raskt i sikkerhet. Byggforskserien beskriver utforming av ledesystem i flukt- og rømningsveier, samt andre tiltak som kan lette rømning fra bygninger.

I dag blir prøvene du tar hos legen analysert i et laboratorium. Og det kan drøye før svaret er klart. Nå kommer laboratorier som ikke er større enn et betalingskort og gir svar på flekken.

Det finnes en uendelig mengde data på internett, som kan brukes til å trene KI-modellene bak ChatGPT. For industriens prosesser er virkeligheten mer utfordrende.

SINTEF presenterer det siste innen forskningsfronten på hydrogen under EU Hydrogen Week 2024.

Norge samarbeider med land med lavere økonomiske forutsetninger slik at disse kan bidra til å løse klimaproblemene på måter som er tilpasset deres ønsker og behov.

Etter åtte år med banebrytende forskning nærmere NCCS – det norske forskningssenteret for karbonfangst og -lagring (CCS) seg slutten.

Et nytt kompetansesenter vil gjøre det enklere for bedrifter og forskningsorganisasjoner å få tilgang til teknologi og infrastruktur i Norge og Europa.

Ingen andre enn de nærmeste naboene ville noen gang ha hørt om kjernekraftanlegget Fukoshima - om det hadde vært plassert under bakken.

Pasienter med multippel sklerose (MS) og Parkinson kan bli bedre om de trener med høy intensitet, fordi det aktiverer nervesystemet og gir økt styrke. Nå utvikler forskere en app som skal gjøre treningen mer effektiv på hjemmebane – med...

Mona Mølnvik, forskningssjef ved SINTEF, har blitt utnevnt til OG21 Technology Champion 2024

Å fange lusa før den setter seg på fisken kan forbedre fiskevelferden og redusere behandlingsindusert dødelighet. Nå skal SINTEF Ocean lede et prosjekt hvor det skal undersøkes i hvor stor grad dette er mulig.

Moderne sensorer, droner og satellitter kan hjelpe oss med å varsle ekstremvær og naturfarer. Dermed kan de redusere konsekvensene for kritisk infrastruktur og i samfunnet ellers.

Regjeringen presenterte et vernedokument med mange løse lovnader om ting som er på gang. Prosesser. Vurderinger. Forslag.

Fiskevelferd: Ved hjelp av et digitalt øye og kunstig intelligens har forskere funnet en måte å overvåke laksens pust på. Det kan avsløre om fisken er stresset eller glad.

Kan vi stole tekst og bilder i framtida? Deepfake brukes til uskyldig moro – men også til å påvirke velgere i verdens mektigste land.

Klimaforskere mangler ofte nødvendig informasjon for beregningene sine. En masterstudent bidro til å finne viktige tall fra Afrikas mest befolkningsrike land.

Et urbant fordrøyende tak kan både være et attraktivt uteareal og et instrument for å håndtere overvannet. Men riktig prosjektering er avgjørende.

Bygg- og anleggsnæringen kan kutte store utslipp ved å holde produkter og ressurser i omløp. Da trenger vi insentiver og rammer som legger til rette for at forskningsresultater raskt kan omsettes i skalerbare, sirkulære løsninger.

SINTEF Ocean og Global Centre for Maritime Decarbonization (GCMD) har signert avtaler om felles innsats for å gjøre maritim sektor grønnere. Partnerskapet vil få fart på maritim avkarbonisering.

Forbehandling inngår som en arbeidsoperasjon for mange av reparasjonsmetodene som benyttes ved rehabilitering av betongkonstruksjoner. Ofte er det nødvendig å kombinere flere forbehandlingsmetoder for å oppnå ønsket resultat.

Datainnsamling har nå startet ved to norske elver for å finne ut hvordan man kan forbedre både kraftproduksjon og miljøforhold.

Digitale teknologier gir industrien mange muligheter, men hvordan lykkes med dette i praksis? I den nye boka «Digitalization and Sustainable Manufacturing – Twin Transition in Norway» belyser forskere hvorfor og hvordan.

– Den som har lært mest når han dør, vinner, sa oljefondssjef Nicolai Tangen fra scenen i samtale med Alexandra Bech Gjørv, under liveinnspilling av Smart forklart på årets Digital fremtid.

Utnevnelsen anerkjenner hennes betydelige bidrag innen høytemperatur elektrokjemiske konverteringsteknologier for bærekraftig kjemikalie- og kraftproduksjon, forskningstemaene hun nå er utnevnt til sjefforsker for i SINTEF, et av Europas største...

Et nytt samarbeidsprosjekt skal se på løsninger for CO2-transport og -lagring for å få fortgang på CCUS-satsning i nord. Nå har prosjektet fått bevilget offentlig støtte.

Mona Mølnvik, forskningssjef i SINTEF, mottok Green Award under GHGT-konferansen i Canada.

Hvordan kan vi øke forståelsen og engasjementet for miljøvennlig arkitektur? Mye tyder på at visualisering ved hjelp av AR kan hjelpe oss.

Klimaregnskap for bygg er et effektivt verktøy for å nå klimamålene. Nå må kravene følges opp med politikk.

Lenge har det vært en gåte: Tonnevis av ferromangan – et viktig tilsetningsstoff i stål – blir daglig «innelåst» i slagg på sin vei ut av smelteovnene. Nå er vi i ferd med å løse problemet.

Et nytt verktøy for vurdering av naturbaserte løsninger vil gjøre kommunene i stand til å ta bedre beslutninger når det gjelder klimatilpasning.

Budskapet kommer fra Atle Harby, seniorforsker i SINTEF. Han er med i ekspertutvalget som skal se på de samfunnsøkonomiske konsekvensene av klimaendringene.

For at de skattene som ligger i våre bygg fortsatt kan brukes trygt videre i sitt neste liv, bidrar SINTEF med sin ekspertise inn i Digital plattform for ombruk av byggematerialer.

Han er blitt kalt karbonfangstens far og har fortsatt tro på at menneskeheten vil klare å komme seg ut av rotet rundt global oppvarming.

Skal vi utnytte mulighetene, styrke vår konkurransekraft internasjonalt og være posisjonert for bioteknologiens «ChatGPT moment», trenger vi en ambisiøs politikk for den fremvoksende teknologi-drevne bioøkonomien.

– Vi må dele kunnskap for å lykkes, sa samferdselsminister Jon-Ivar Nygård fra scenen under årets ZERAC24. Konferansen bringer nøkkelaktører sammen med mål om å fremme mer klimavennlig flytransport.

Nanomedisiner redder liv – men de kommer seg ikke fort nok ut på markedet og inn i kroppen til pasienten. Nå har forskerne laget oppskriften på hvordan det kan gjøres raskere og bedre.

SINTEF jobber mot bevaring av naturmangfold og lavere arealbruk gjennom teknologiutvikling og innovasjon. Det krever et tett samarbeid mellom tverrfaglige forskningsinstitusjoner, næringsliv og forvaltning.

SINTEF legger frem rapporten "Teknologi for raskere global klimaomstilling” under årets klimatoppmøte COP29 i Aserbajdsjan.

Vi må tenke nytt for å få unna alt vannet som kommer til å komme. Nå er en ny kombinert infiltrasjons- og fordrøyningsløsning testet i fullskala på Torvet i Trondheim.

For første gang i Norge er det utviklet en metodikk for hvordan en kan planlegge for nullutslipp i hele områder, ikke bare for hus.

SINTEF Energi har gleden av å meddele at Gard Hopsdal Hansen blir den nye lederen av forskningssenteret FME NorthWind.

Et EU-finansiert prosjekt vil forbedre datasentrenes energieffektivitet og bærekraft ved å transformere energistyringen med innovativ nedsenkingskjøling.

SINTEF-forskere har kartlagt hvilken og hvor mye biomasse i Norge som kan brukes til bioenergi med karbonfangst (bioCCS), en metode for å fjerne CO2 fra atmosfæren. Metoden kan kutte mellom 4 og 16 % av Norges utslipp.

Har du lyst til å være med og skape fremtidens energiløsninger? Nå har du sjansen til å utforske en forskerkarriere hos SINTEF, et av Europas ledende forskningsinstitutter.

Hils på roboten «Bifrost». Ved hjelp av KI har den fått taktile evner som gjør det mulig å forme myke objekter på bestilling. Det er verdensrekord.

Å utnytte større deler av havets potensielle matfat krever ny kunnskap og ny teknologi. Men hvor og når det lønner det seg å fiske etter nye arter som raudåte (Calanus)? Da behøves store datasett.

Cyberangrep, teknologisk krigføring, helserevolusjon og behov for kunstig intelligens i industrien. Forskning på fremtidens teknologi er viktigere enn noensinne.

Forsvaret er i dag en storforbruker av fossilt drivstoff. I framtiden kan Forsvarets drivstoff komme fra norske gårder og hogstfelt.
Kjøkken bygges ikke som våtrom, og vanntilkoblede maskiner gjør kjøkkenet mer utsatt for skader enn før. Bransjepraksis og ulik tolkning av byggteknisk forskrift (TEK) fører til mange dårlige løsninger.

SINTEF-forskere måler helseeffektene av å gå, sykle og kjøre elsparkesykkel til jobb. Det gir Statens vegvesen et bedre beslutningsgrunnlag når de utvikler transportsystemet.

Det viser erfaringer fra flere klimaambisiøse prosjekter.
Mange store oppdagelser og oppfinnelser springer ut fra grunnforskning. Særlig innenfor medisin, men også fra mange andre fagfelt. Her er noen av dem.

I prosjektet NADA får kommuner hjelp av forskere til å analysere avfall på byggeplassene, slik at de skal kunne levere bygg til befolkningen uten å generere store avfallsmengder. Målet er null avfall.

En ny ørepropp kan fungere som både hørselsvern, musikk-avspiller og mikrofon – samtidig! Sentralt i teknologien står en MEMS-brikke som SINTEF har utviklet sammen med Minuendo AS.

Om lag en av ti norske kvinner blir rammet av endometriose, en sykdom som kan gi invalidiserende smerter. Et nytt forskningsprosjekt skal bruke kunnskap fra kreftbehandling til å utvikle nye diagnostiserings- og behandlingsmetoder.

Er du bitt av løpebasillen? Da har du kanskje lurt på akkurat dette spørsmålet. Her får du svar.

Testingen er med på å sikre vanntette vegger i våtrom.

Det viser årets Young Professional Attraction Index (YPAI) fra Academic Work, som kartlegger unge i arbeidslivet og rangerer årets mest attraktive arbeidsgivere blant studenter, nyutdannede og de som er inntil fem år inn i karrieren.

Skolene våre må i større grad stimulere elevenes trivsel, motivasjon og lærelyst. På dette seminaret i universitetsbyen Tromsø diskuterer vi veien framover.

Nyvinningen kan sette fart på nødvendig karbonfangst i en rekke industrier. Teknologien ble nylig demonstrert ved et avfallsforbrenningsanlegg i Bergen, med gode resultater.

Fornebu går foran når byene våre skal bli klimanøytrale. Pilotprosjekter viser hvordan en slik omstilling kan gjennomføres i praksis.

SINTEF Digital har landet tre nye Pathfinder-prosjekter på ett år. – Veldig gledelig når vi vet at nåløyet er svært trangt, sier konserndirektør i SINTEF Digital.

DigiPro Centre tar nå ledelsen i et sekretariat som på oppdrag fra Prosess21 skal beskrive muligheter og utfordringer ved digitalisering i prosessindustrien frem mot 2030.

Nanomedisin med gassbobler har vist seg å være en unik måte å transportere cellegift inn i lungene til kreftpasienter. Metoden gjør presis og konsentrert behandling mulig – og hindrer samtidig en rekke bivirkninger fordi den bare virker lokalt.

Alkalireaksjoner i betong reduserer levetiden til konstruksjonene. Forskningsinnsatsen som er lagt ned ved SINTEF og NTNU gjør oss nå i stand til å bygge mer bærekraftige betongkonstruksjoner.

Vi skal fortsette å bygge moderne boliger – også de med flate tak. Men klimaendringene vi står oppe i krever nye løsninger, nye materialer, riktig dokumentasjon og at vi ikke glemmer overvannshåndtering.

Hvor høy prosentandelen av batterikapasiteten i en elbil bør lades, om målet er lang levetid på batteriet? Ny forskning på nikkelrike katoder kan gjøre framtidas batterier enda bedre – og øke levetiden på de vi allerede har.

Nå kan alle interesserte laste ned data fra vår åpne skipsdesign og testplattform SINTEF Ocean Bulk Carrier (SOBC-1) for bruk i forskningsprosjekter og casestudier, for eksempel innen grønn skipsfart.

Arbeidsplasser som legger til rette for god integrering av arbeidsliv og privatliv, får ansatte som trives og presterer bedre, ifølge forskning.

En kunstig «nese» fra Norge beskytter astronautene mot giftige gasser. Nå skal den til månen. Kanskje helt til Mars.

På konferansen «Havneomstilling: samhandling for et bærekraftig taktskifte» i Trondheim 13. og 14. november, skal vi dele kunnskap og erfaringer for å realisere fremtidens bærekraftige havnesektor.

Gjennom to forskningsprosjekter skal SINTEF undersøke hvilke erfaringer verneombud og medlemmer i AMU har med HMS-opplæring. Svarene vil bidra til ny kunnskap om HMS-opplæring i norsk arbeidsliv.

Flere kan klare seg uten å kjøre så mye bil, men da må boligområdene planlegges slik at det blir enklere. Astrid Bjørgen har forsket på hvordan.

Havbruksnæringens historie er preget av prøving og feiling i raskt tempo. Denne tilnærmingen har gitt oss mange gode løsninger, men for videre utvikling av næringen vil også andre metoder for produktutvikling ha stor verdi.

Politikk og retningslinjer som inkluderer naturbaserte løsninger og legger vekt på samarbeid, er viktig når vi skal skape mer klimarobuste samfunn. Lær mer i en ny podkast.

Ny norsk teknologi kan avsløre kvaliteten på mRNA, budbringermolekylet som på rekordtid har blitt et våpen mot svært mange sykdommer. Høy kvalitet i dette leddet er helt avgjørende for denne typen medisiner.

Norge har en ambisjon om å ta lederskap på bærekraft i hele verdikjeden for batterier. Flere initiativer er igangsatt, men hvordan kommer vi til det nivået som trengs for at målet nås?

Ute av syne, ute av sinn? Langt i fra. Tiss, bæsj og dopapir er det eneste som skal i do. Alt annet påvirker livet i havet.

Det nye Pilot-E prosjektet MaksGrid skal teste ut løsninger som til sammen vil kunne øke utnyttelsen av strømnettet med 25 prosent.

På syv år har én ansatt blitt til 16, og over 150 store og små forskningsprosjekt er gjennomført på Nordvestlandet. Nå satser de lokale forskerne videre når SINTEF Ålesund skifter navn til SINTEF Nordvest.

Små endringer på et velfungerende kaldt loft kan gi store kondens- og muggsoppskader. For å hindre skader er det viktig å velge riktige materialer og utbedringsløsning.

Målet er å redusere vannforurensing i byer ved hjelp av et digitalt analyseverktøy

I alle fall om du vil opp og fram i bedriften. Her får du vite hvorfor.

Hvordan kan naturbaserte løsninger hjelpe oss med å tilpasse oss og dempe virkningene av klimaendringer i kalde områder? Dette er tema i en ny podkast.

– Vi trenger at kommunestyrene der ute forstår sammenhengen mellom inneklima og læring.

Prosessindustri, karbonfangst og -lagring og bioteknologi var hovedtemaene på arrangementet Industriløftet på Arendalsuka 2024.

To sekunder med oppmerksomheten rettet mot noe annet enn trafikken, dobler faren for ulykker. Navigasjon på skjerm utfordrer oss mest.

To nye laboratorier skal teste energisystemer som skal gjøre skipsfarten grønn, og konstruksjoner som er nødvendige for havvind og annen energiutvikling offshore.

Energisamfunn bestående av kontorbygg og butikker, gjerne i miks med husholdninger, kan gi oss billigere strøm. Samtidig reduserer det belastingen på strømnettet.

Mange gamle trebjelker kan gjenbrukes i bærekonstruksjoner i nye bygg. Men hvordan kan vi sortere brukte bjelker bare etter utseendet?

I 2024 er det ti år siden nobelprisen gikk til NTNU og Edvard og May Britt Moser. Det markeres med et spesialnummer av forskningsmagasinet Gemini.

Veien mot selvkjørende kjøretøy krever teknologisk og juridisk nyvinning.

Forskere har sett på faren for å overføre prionsykdommer om man mater laks med børstemark fôret med fiskeslam. Et kjent eksempel på en prionsykdom er kugalskap.

Strømforsyningen i Norge er i dag svært pålitelig, men står overfor nye utfordringer. For å sikre at vi har kontroll på forsyningssikkerheten har vi tre råd til norske politikere.

SINTEF Industri bidrar med nye forskningsresultater og kunnskap i flere sentrale debatter på Arendalsuka i år.

Norge må ta flere grep for å sikre strømforsyningen i framtida. Her er tre råd om hvordan det kan løses.

SINTEF har hatt en sentral rolle i utviklingen av en innovativ tilnærming for testing av bølgekraftkonvertereres pålitelighet, ytelse og levetid.

Det Europeiske Investeringsfondet (EIF) girer opp innsatsen i norske teknologistartups og gjør sin tredje og hittil største investering noensinne i SINTEFs såkornfond.

Enkle metoder for romoppvarming utenfor spisslasttimene kan bidra til å skape mer energifleksible bygg. Dette kan gjøres uten at termisk komfort går tapt, viser ny forskning.

SINTEF gir forskningsbaserte energiråd på Arendalsuka for niende gang. Tema i år er blant annet forsyningssikkerhet, klimafiksing, CCS, energisløsing, datasentre, energidugnad og havvind.

Unge som har en vanskelig oppvekst og sliter kan ha stor nytte av å mekke og skru, viser forskning. For noen blir det et vendepunkt i livet.

Det haster med å finne varig og standard praksis for sirkulære løsninger. For å komme i mål kreves det koordinert innsats fra alle aktører i byggenæringen, inkludert politiske beslutningstakere.

Kraften fra bølgene kan supplere vindkraft, men har også et stort potensial i seg selv.

En milepælsnyhet på hydrogenområdet kommer nå fra Köln, hvor Shell har tatt en endelig investeringsbeslutning om REFHYNE II, en 100-megawatt elektrolysør ved Shell Energy and Chemicals Park Rheinland i Tyskland.

Handleposen er grei å ha på handleturen – men ikke bruk den til oppbevaring av mat. Det er den klare advarselen fra forsker Lisbet Sørensen i SINTEF.

Ingen er glad i kø. En norsk gjennomsnitts-bilist er villig til å punge ut med nesten 100 kroner for å spare én time i trafikken, ifølge forskning. Men køa kan temmes.

Trenger du noe å gjøre i ferien? Har du ikke fri, men kjeder deg på jobb? Bryn deg på Geminis sommerquiz!

Alle blir sjøsyke, men det finnes knep for å unngå elendigheten, sier forsker Toralf Sundin Hamstad i SINTEF.

For mye av plasten i havet i Norge kommer fra fiskerinæringen. I alle fall om vi ser på vekt. Tau. Garn. Bøyer. Isopor. Klær.

Politikkutformingen går i riktig retning, men det trengs en mye større satsing for å utløse det store potensialet for energieffektivisering i bygningsmassen. Ambisjonene må opp!

I disse dager høstes den første taren som har fanget og bundet karbon siden juletider i et havanlegg på Trøndelagskysten. I den anledning fikk vi besøk av Fiskeri- og havminister Marianne Sivertsen Næss.

Mannskapsmangel i Ferge-Norge gir mange innstilte avganger. Kontrollrom på land og ny sikkerhetsteknologi er noe av det som kan åpne for seiling med lavere bemanning.

Får vitenskapelig og strategisk ansvar for teknologier for produksjon, gjenvinning og resirkulering av kritiske og strategiske råmaterialer fra primære og sekundære kilder, samt fra mineraler.

Er du redd for at fri og ferie vil gjøre deg dummere i løpet av sommeren? Fortvil ikke, podkasten «Smart Forklart» gir deg fortløpende episoder med fakta du kan briljere med rundt rekebordet.

Etter tre år med venting skjedde det: Forskere fikk den røde sjøpølsa, som regnes for å være verdens dyreste sjømat, til å gyte i laboratoriet.

Det nye prosjektet INCA (Increased Capacity in the Cable Grid) skal bidra til mer effektiv drift av kraftnettet.

Rådene skal sikre at skoleanlegg planlegges og bygges til beste for lokalmiljøet.

Når teknologioptimistene er de eneste som tester KI, blir ikke resultatene gode nok. Her gjorde Tesla en stor feil, som helsevesenet nå kan lære av.

Hvordan sikre Norge mot energikrise? Er kunstig intelligens klimaversting eller reddende engel? Og hvordan kan vi skape og utvikle nasjonale kunnskaps- og teknologifortrinn i en ny geopolitisk situasjon? Dette og mye mer kan du høre om dersom du...

Store mengder digitale data trengs for å kunne bruke kunstig intelligens i materialforskning. Den internasjonale standarden, OPTIMADE, gjør det mulig for forskere å kommunisere med alle relevante databaser.

Når solcellepaneler erstatter taktekning eller kledning, kalles det bygningsintegrerte solceller. De må oppfylle samme bygningstekniske krav som elementene de erstatter, blant annet til fuktsikkerhet.

Oppdretterne skal ikke tjene på dårlig fiskevelferd – men er det fornuftig og mulig å utnytte fisk som av ulike årsaker dør i merdene på en bedre måte enn i dag?

Kun en av tre kommuner sjekker tilgjengeligheten på skolene sine. Norges Handikapforbund krever raske tiltak.

18. og 19. juni trakk en ny konferanse om hydrogenforskning 132 hydrogenforskere og bransjefolk til Trondheim.

Et nytt forskningsprosjekt i EU skal bidra til mer nøyaktig og standardisert informasjon om byggematerialer og deres egenskaper. Målet er mer ombruk i byggenæringen, og SINTEF leder piloten på Svalbard.

Solcellepaneler inneholder mange verdifulle materialer. Allikevel går det meste på dynga etter endt levetid. Nå jobber forskere med saken.

Fullstendige bærekraftige verdikjeder, industri- og forskningssamarbeid og teknologiutvikling var blant hovedpunktene under SINTEFs deltakelse på Industriuka 2024.

Parallelo, Rodeo arkitekter, NTNU og SINTEF har fått midler fra Forskningsrådet til å utvikle et analyseverktøy som måler klimagassregnskapet til boligprosjekter.

En engasjert gjeng fra de 13 partnerne i Grønn plattformprosjektet MegaCharge møttes for å starte opp arbeidet med en komplett verdikjede for utvikling av ladeinfrastruktur for elektrisk tungtransport.

Ved å forbedre rapportering av fangstvolumer og fiskehelse i europeisk fiskeri, håper EU-prosjektet OptiFish å bidra til mer bærekraftig fiske og gjøre det enklere å møte eksisterende og fremtidige kontrollkrav.

Svære mengder knust stein blir til overs ved mineralutvinning og ender i naturen. Om vi utvikler ny kunnskap, kan slik masse i stedet brukes i betong og til å forbedre dyrkingsjord.

Den europeiske organisasjonen for kvalitet (EOQ) tildeler Alexandra Bech Gjørv, konsernsjef i SINTEF, European Quality Leader Award 2024. Denne utmerkelsen anerkjenner hennes arbeid med risikostyring og kvalitetsledelse i SINTEF.

Mange opplever HMS-arbeidet i havbruksnæringen som «brannslukkende», men noen av de nye bedriftene er i forkant, ifølge en ny undersøkelse. For å bistå næringen i det systematiske HMS-arbeidet, lanserer SINTEF Ocean nå siden HMS i havbruk (www...

Økte forventninger om CO2-fangst og lagring krever mer forskning på sikre og kostnadseffektive metoder for lagring i stor skala. Ved Svelvik CO2 Field Lab får industrien og forskere teste ut avgjørende teknologi for overvåking av CO2-lagring i...

SINTEF Helgeland skal delta i et spennende prosjekt om økt bærekraft og sirkulærøkonomi i industrien gjennom å etablere en Hub for Circularity.

Det hevdes at Europa ikke er gode på teknologi, sammenliknet med USA, Kina og Taiwan. Det stemmer ikke, ble det sagt under åpningen av konferansen «The Sensor Decade». Paneldeltakerne var enige om at Norge nå må tørre å ta risiko og investere for å...

Verden er avhengig av et livskraftig hav. For å kunne utnytte havet på en forsvarlig måte må vi forstå det.

Mens jordbærbonden sover, kjører en robot rundt og skanner alle bærene. Neste morgen forteller roboten hvor søte jordbærene er – og når det er lurt å plukke dem.

Alt tyder på at vulkansk pozzolan fra Island kan erstatte store deler av klinkeren i fremtidens betong.

For å utvikle digitale tvillinger, beslutningsstøtteverktøy og tjenester for smarte byer og infrastruktur, trenger vi informasjon om bygninger og områder.

Samarbeidsavtalen bidrar til lett tilgjengelig produktdokumentasjon for byggenæringen.

Vi må sannsynligvis reflektere sollyset bort fra jorden, mener SINTEFs Nils Røkke. Men løsningen, som kalles geoengineering, er kontroversiell.

I prosjektet Smart Journey Mining følger forskerne de digitale fotsporene til veis ende. Det gir gründerne unik innsikt i den totale kundeopplevelsen. Og fornøyde kunder kommer gjerne tilbake!

Forskere ved SINTEF har utviklet en prototyp for en chatbot som baserer seg på kunnskap fra forskningssenteret Klima 2050.

Datasentre bruker mye kraft, så vi må sikre gjenbruk av overskuddsvarmen. Det frigir mye strøm til annen bruk.

Norsk havnesektor er fragmentert. For å nå klimamålene er det behov for en nasjonal havnepolitikk og tydeligere ansvarsfordeling mellom ulike aktører.

Norske jenter trives i stor grad på skolen, mens guttene har en markant dårligere opplevelse av skolemiljøet. Et av problemene er at guttene opplever skolen som urettferdig.

Bli med til laboratoriene og testarenaene hvor bedrifter og forskere møtes for å utvikle og teste nye produkter og tjenester. Du vil få innsyn i det unike samspillet som foregår og kanskje oppdage nye muligheter for din bedrift eller innovasjon.

Hvordan kan vi ruste Norge mot fremtidens ekstremvær? Den nasjonale konferansen for klimatilpasning samlet 300 aktører på tvers av sektorer og fagfelt for å finne løsninger.

Det danske kongeparet, det norske kronprinsparet og fem statsråder fra Norge og Danmark besøkte UiO og SINTEFs MiNaLab og Oslo Science City på det danske kongeparets første statsbesøk som Konge og Dronning av Danmark.

Kan man bruke det vanlige komfortventilasjonsanlegget til å trekke ut røyk og begrense skader når det oppstår brann i et skolebygg? Ny forskning viser at nei, dette er ikke en sikker strategi.

EU-CIP (Critical Infrastructure Protection) er et europeisk samarbeid for å beskytte kritisk infrastruktur.

De siste 15 årene har klebeprodukter, og spesielt teip, gjort sitt inntog på det norske markedet. Manglende kunnskap om hvordan teip og klebeprodukter fungerer generelt – og over tid – har blitt kartlagt i et forskningsprosjekt ved SINTEF.

Akkurat slik Stavanger i sin tid tok grep og ble “oljehovedstaden”, har Trøndelag nå en gyllen sjanse til å skape et industrielt tareeventyr.

En ny veileder viser hvordan man bør gå fram når man vurderer å etablere grønne tak på eksisterende bygg.

Allerede neste år vil det rulle hundre hydrogenlastebiler her til lands. Med null klimagassutslipp, og en rekkevidde på 500 kilometer. Dessuten: Full tank sikres på mindre enn femten minutter.

Hvordan vil et måltid bestående av havsalat, tare, snegler, tanglopper og sjøpølse se ut? Og kan slike råvarer friste Michelin-kokker fra Belgia og Nederland? Det kan se sånn ut.

Ja, ifølge «Veikart for taredyrking i Trøndelag» som ble lansert på Frøya 8. mai. Tilstede var representanter for Trøndelag fylkeskommune, WWF, Blått kompetansesenter, Frøya kommune, og selvfølgelig SINTEF Ocean som utarbeidet veikartet for...

De er tunge, stive og først og fremst laget for å beskytte. Mange opplever den rett og slett som en plage. Men nå skal forskning bidra til mer ergonomiske vernesko, samtidig som klimaavtrykket skal ned.

Kamilla Heimar Andersen, ansatt i SINTEF og doktorand ved Aalborg Universitet, vil forbedre energiforbruket i boligblokker gjennom avansert analyse av brukeradferd og tekniske anlegg.

800 milliarder kroner kan det koste å plugge de norske olje- og gassbrønnene når de går tomme. En ny fremgangsmåte med vismut kan være både mer effektiv og billigere.

Hva er et moderne og smart strømnett? Hva skjer hvis strømnettet blir overbelastet? Og hvordan ser fremtidens strømforsyning ut?

Flere pilotprosjekter viser at det er fullt mulig å få ned utslippene i anleggssektoren. Men for å ta ut hele potensialet trengs det mye mer kunnskapsdeling i bransjen.

I 2023 skjedde det mye i FME ZEN. Beviset for det finner du i årsrapporten som nå er klar.

I en tid med stort behov for nye løsninger holder forskningsvirksomheten i SINTEF bare så vidt tritt med inflasjonen. SINTEF utførte forskning for 4,2 milliarder kroner i 2023, gjennom 6.371 prosjekter for 3.341 oppdragsgivere.

Teknologien vil bli stadig viktigere for Europas evne til å forsvare seg. Ved hjelp av en digital tvilling kan problemer om bord marine fartøy avverges før de inntreffer.

Om vi etteraper naturen, kan vi kanskje utvinne havbunnsmineraler ved å hente varmt vann opp fra jordskorpa. Pluss høste grønn energi samtidig. Alt dette på skånsomt vis.

I en verden hvor både tradisjonell sikkerhet og klima spiller en stadig større rolle, er det ekstra viktig med internasjonalt samarbeid. Tirsdag 16. april møttes de øverste lederne av Kystvakten i sju nasjoner i regi av Arktisk Kystvaktforum (ACGF) i...

Når studenter, forskere og næring går sammen om å klimatilpasse boligene våre, finner de løsninger som ikke ellers hadde vært like åpenbare.

Ved å erstatte naturgass med bærekraftig hydrogen og sikrere og smartere produksjonsmåter, skal et EU-finansiert prosjekt avkarbonisere glass- og aluminiumsindustrien.

Nå skal snart brukte og returnerte plastrør trygt og enkelt kunne klargjøres for ombruk. Leverandører, rådgivere og rørleggere samarbeider med forskere om å utvikle vurderingsmetoder som gjør dette mulig.

– 11. april kunngjorde Forskningsrådet en investering på 180 MNOK i et nytt forskningssenter for karbonfangst, -transport og -lagring (CCS) i Norge.

Glass blir stadig mer brukt i norske byggverk, i fasader, som tak og som rekkverk. Parallelt med den økte bruken, får vi i SINTEF også flere henvendelser om skader på glass.

Naturbaserte løsninger har mange fordeler når vi skal tilpasse oss et klima i endring.

Formelverk fra 1950-tallet forhindrer full utnyttelse av strømnettet. Digitale hjelpemidler alene vil øke kapasiteten med 20 prosent i kabeldelen av nettet, viser ny forskning.

Å få fortgang på den grønne omstillingen av maritim sektor, redusere energiforbruket og erstatte fossile med fornybare drivstoff er ingen enkel oppgave. Nå skal et nytt forskningssenter, FME MarTrans, sette fart på utviklingen.

Om vi skal nå målene for energieffektivisering i bygg innen 2030, kan vi ikke vente på økte midler. Vi må bruke tiden på å finne de beste tiltakene og utnytte potensialet som ligger i digitalisering.

Energiminister Terje Aasland kunngjorde 11. april etableringen av et nytt forskningssenter som skal se på hvordan man kan redusere både kostnader og naturpåvirkning i energiomstillingen.

En ny rapport fra SINTEF viser hvordan slake, luftede tretak med innvendig nedløp for takvannet kan utføres.

Mer enn 1 000 000 tonn restråstoff fra fiskerinæringen kan redde mat- og kosmetikkbransjen fra råvaremangel og skape nye arbeidsplasser. Stikkord: omega 3-rike marine oljer, kollagen og gelatin.

Ny forskning kaster lys over store utfordringer og barrierer når det gjelder tilgang til psykisk helsehjelp for barn og unge i barnevernet. – Vi kunne tydelig se barn, unge og foreldres misnøye med tjenestene, sier seniorforsker i SINTEF, Marian...

Det nye forskningssenteret FME SecurEL skal utvikle et sikkert, motstandsdyktig og bærekraftig strømnett.

Norges forskningsråd tildelte i dag åtte nye Forskningssentre for miljøvennlig energi (FME). NTNU og SINTEF leder eller deltar i alle sentrene. Den totale finansieringen fra Forskningsrådet er 1,28 milliarder kroner over åtte år. Hvert senter vil i...

En landsomfattende spørreundersøkelse avdekker at folk som får behandling for rus og psykiske problemer i det store og hele er fornøyd med hjelpen de får. Men alt er ikke like rosenrødt.

Tjenesten er testet ut i Molde og Ålesund, nå vil SINTEF og teknologiselskapet Nimmo se på mulighetene for å oppskalere.

Ved å omdanne restprodukter fra skogbruksindustrien til proteiner for fiskefôr, kan både skogbruk- og fiskefôrindustrien oppnå et mer klimavennlig og høykvalitetsprodukt.

Ny kunnskap belyser hvilke strategier som trengs for å fremme økt ombruk av byggematerialer.

Høy andel fornybar energi og høy energieffektivitet er avgjørende i utviklingen av nullutslippsområder. Energibruk og elbillading er blant løsningene Åse Lekang Sørensen forsker på.

Norske politikere bør ikke sponse det pågående KI-kappløpet. Det tar for mye energi.

Bedre retningslinjer for måling av sirkularitet vil være et skritt i riktig retning. Det viser en kartlegging utført ved forskningssenteret FME ZEN.

FME ZEN er et forskningssenter for miljøvennlig energi som skal utvikle løsninger for framtidas bygninger og områder – løsninger som bidrar til at nullutslippssamfunnet kan realiseres.

Et toårig forskningsprosjekt skal bidra til en mer bærekraftig ressursutnyttelse, et lavere klimaavtrykk, og økt samarbeid og konkurransekraft rundt Norges nasjonalbergart larvikitt.

Er du klar for noen skikkelig vriene spørsmål? Da er du klar for vår eggstremt vanskelige påskequiz.

Forskere har funnet ut hvordan man kan bruke alger til å omdanne ammoniakk og nitrat til næringsrik gjødsel eller fôringrediens.

Gaia Arctic Summit 2024 skal samle internasjonale eksperter og næringslivsledere 6.-7. juni, for å utforske muligheter knyttet til klimaendringene i havet og kystsamfunnene i nord.

Først satte pandemien en voldsom fart i hackerne. Så kom krigen i Ukraina. Rita Maria Ugarelli, ekspert på sikkerhet i vannforsyningen, har avtaleboka full til jul.

Slepetanken på Tyholt, Trondheim, åpner igjen denne våren etter installasjonen av en splitter ny bølgemaskin.

Byggenæringen står i dag for hele 25 prosent av avfallet som produseres i Norge. En ny veileder viser vei mot avfallsfrie byggeplasser.

Vanlig avl gir store og ukontrollerte endringer i arvematerialet til dyr og planter. Skulle “føre-var-argumentet” brukes like blindt her som i genteknologidebatten, ville verden sulte.

Mer forskning, lokal produksjon og tilgang til materialer er nødvendig for å kunne sikre Norge en ledende posisjon innen bærekraftige batterier.

Nei, det skal ikke handle om ventilering av tilfluktsrom, men at de viktige forholdene som ventilasjons- og inneklimabransjen jobber med ikke må bli glemt blant alt som konkurrerer om oppmerksomheten.

Å spise mer tang og tare kan være en løsning som både er sunn og bra for planeten vår. Men hvordan kan vi få til det?

Hvorfor sliter vi med at gode intensjoner går tapt i prosessen fra tidlig planlegging til ferdig bygg? Nå har forskere sett på saken.

Trøndelag fylkeskommune har siden 2018 jobbet med nullutslipp fra drift av sine skolebygg. På Mære landbruksskole går CO2-utslippene ned år for år.

Når du skal kjøpe nytt kjøleskap, tørketrommel eller varmepumpe, har du som forbruker en unik mulighet til å påvirke miljøet positivt. Forskning fra SINTEF viser at valget av kjølemedium spiller en viktig rolle i kampen mot global oppvarming og...

Partnere fra hele verdikjeden går sammen for å teste og ta i bruk alternative materialer i vegbygging.

Forskere bidrar med å teste og sikre gammelt murverk når verneverdige Sophies Minde i Oslo rehabiliteres. Resultatene viser at mye kan brukes om igjen.

Når klimaet endrer seg, endres også nedbørsmønster, avrenning og temperaturforhold. Dette gir både nye utfordringer og muligheter for norsk vannkraft.

Kvinners helse og kropp har lenge vært et nedprioritert forskningsområde. Men en helt spesiell teknologi kan blant annet gi oss ny behandling av kvinnesykdommen endometriose.

Google-senteret i Skien kan komme til å fyre for kråkene – vi mangler lovverk som reduserer faren for at overskuddsvarme går til spille. Det bør vi gjøre noe med.

Trond Runar Hagen (47) trer inn i stillingen som konserndirektør og leder for SINTEF Digital.

Reisen mot utslippsfrie bygge- og anleggsplasser i Norge begynte allerede i 2017. Nå har forskere kartlagt tre viktige faktorer som driver transformasjonen.

Norge er i verdenstoppen på bruk av robotikk i oppdrettsnæringa. Hvordan påvirker det tekniske utstyret fisken? Overraskende mye, sier kybernetiker Eleni Kelasidi.

Droner, maskinlæring og varslingssystemer skal hindre trafikkulykker med hjortevilt. Forskere går sammen med Statens vegvesen og gründerbedrift for å se på nye løsninger.

Alenefiskeren som falt over bord sist fredag, døde. Han ble yrkesfisker nummer 156 i rekken siden årtusenskiftet i 2000. – Dette understreker budskapet i rapporten vi nylig publiserte, sier sikkerhetsforsker i SINTEF.

Gjør det noe om et stykke sjelden myr går tapt der det er mye av den? Umulig å si, for ingen oversikt viser om slik myr ødelegges et annet sted samtidig.

Powertekk takpanner fra Isola er det første produktet som får et eget kapittel om ombruk i en SINTEF Teknisk Godkjenning. Det er en viktig milepæl på veien mot å gjøre byggenæringen mer bærekraftig.

Visste du at den kjemiske industrien praktisk talt forsyner alle andre verdikjeder? Dette inkluderer mat, bygg og anlegg, helse og transport. Men industrien må fornyes i grønn retning. Det jobber vi i SINTEF med.

Kriteriene for frostmotstand i tegl er strenge, og mye av steinen som ikke tilfredsstiller disse, kan være godt egnet til ombruk. Derfor vil vi vurdere stein etter ulike kriterier for ulik bruk.

Norge er i verdenstoppen på bruk av robotikk i oppdrettsnæringa. Hvordan påvirker det tekniske utstyret fisken? Overraskende mye, sier kybernetiker Eleni Kelasidi.

Hvis Europa skal nå sine klimamål, må det til å bli mer havvind i energimiksen. En ting er å produsere alle disse vindturbinene, men en annen utfordring blir hvordan de skal festes eller forankres. Det er ikke nok produksjonskapasitet for...

Halvparten av de som jobber med tannhelse synes det er vanskelig å motivere barn og unge til å passe på tennene sine, ifølge ny undersøkelse. Det kan gå utover helsa til pasientene senere i livet

Dersom regjeringen trosser flertallet i Genteknologiutvalget, glipper en overmoden mulighet for økt matsikkerhet, forbedret dyrevelferd og grønnere plantevern.

SINTEF Certification har nå utstedt de første personsertifikatene for servicepersonell for minirenseanlegg.

Trondheim og Oslo får EU-midler for å jobbe med CO2-fangst og et robust energisystem. SINTEF bidrar med forskning.

Byggforskserien viser hvordan nye bygninger bør sikres mot inntrenging av helseskadelig radongass.

Fornybarbransjen er avhengig av naturens ressurser, som vann, sol og vind. Samtidig påvirker bransjen naturen på flere måter, og de må derfor omstille og tilpasse seg den økende naturrisikoen.

I forbindelse med en foreslått innstramming av kravet til nøyaktig telling av laks og regnbueørret, har forskere hos SINTEF Ocean sett på hvor nøyaktig det er realistisk å telle, og hvilke tiltak som kan bidra til bedre nøyaktighet.

Altfor ofte ser vi at løsningene i Byggforskserien knyttet til ventilerte fasader benyttes uten god nok detaljprosjektering. Dette øker risikoen for byggskader og bruk av lite bærekraftige løsninger.

Til tross for kulde, begrenset infrastruktur og store avstander kan elektriske anleggsmaskiner også tas i bruk i Nord-Norge, viser ny studie.

Kommunar flest driv med klimatilpassing litt her og litt der, men få har oversikt over alt som blir gjort. God koordinering av dette arbeidet er avgjerande for å sikre lokalsamfunna våre mot store skadar frå neste uvêr.

Forskere gjorde et overraskende funn da de analyserte bergarter. De fant en ny og miljøvennlig løsning for å fjerne helseskadelige tungmetaller i vann.

Du har sikkert sett flere sekkedyr (tunikater) enn du tror. De vokser langs hele norskekysten, og kan være til irritasjon når de fester seg på tau eller flytebrygger. Men de kan også vise seg å være nyttige – som laksefôr.

Et godt luftfilter i ventilasjonsanlegget beskytter oss mot forurensning, holder anlegget rent og bidrar til lavere energikostnad. Byggforskserien gir råd om hva man bør tenke på ved valg av filter.

Takflater i byområder er ettertraktet areal. Skal de brukes til energiproduksjon, helse og rekreasjon eller være et sted for å dyrke urter og grønnsaker? Nå må vi utvikle verktøy for å kunne ta riktige beslutninger tilpasset et klima i endring.

I dag står langdistanse sjøtransport for 80-90 prosent av all global handel. Muligheten for å redusere klimautslipp ved å bytte til grønnere drivstoff er derfor svært stort.

Lynnedslag, sterk vind som får trær til å velte over høyspentlinjer, snø og ising gir oss døde stikkontakter. Samtidig står vi foran et stort kraftunderskudd – og mer ekstremvær. Hvordan kan vi unngå full strømkrise?

I ett år har forskerne tatt konkrete grep for å restaurere ødelagte økosystemer fem steder langs kysten av Europa. Allerede nå ser de en effekt som gir mye håp.

Bærekraftig omstilling må høyere opp på agendaen hvis vi skal ha en robust transportinfrastruktur i årene som kommer.

Skal Norge lykkes med å skape verdier for milliarder med kunstig intelligens, må vi satse mer på teknologien og maskinene som skal gjøre jobben.

Det tror i alle fall forskere. I dypet mellom 200 og 1000 meter lever arter som kan være svært verdifulle. Men det er skjær også i dyp sjø: Fangsten forvandles raskt fra gull til gugge.

Brussel: - Norge og EU må samarbeide enda tettere i fremtiden på forsknings- og innovasjonsfronten for å løse alle utfordringene som står foran oss innen kort tid, sa energiminister Terje Aasland på et arrangement organisert av flere norske...

På oppdrag fra Norsk Eiendom har vi sett på kriterier som bør være med i et vurderingssystem for bokvalitet i nye boligprosjekter.

En svært erfaren bioteknologiforsker overtar roret etter Ågot Aakra, som våren 2024 tiltrer en stilling som dekan ved Norges miljø- og biovitenskapelige universitet.

Forskere bruker nå forskningsmetodikk fra olje- og gasstransport for å oppskalere CO2-fangst og lagring. Det er godt nytt for klimaet.

En av landets største suksesser innen praktisk bruk av kunstig intelligens (KI) til nå, handler om å oppdage bruddskader. Formelen som ligger bak, kan anbefales til mange bedriftsledere.

Transport på innlands vannveier regnes med sine lave samfunnskostnader som den nest mest bærekraftige formen for landtransport – bare slått av jernbane. Og når alle transportformer går over til nullutslipp, blir vannveistransport den transportformen...

Familier som fikk hjelp til å kjøpe bolig fikk et bedre liv på flere måter. Men konsekvensene var ikke like positive for de som fikk hjelp til å leie.

De 175 medlemslandene i FNs internasjonale sjøfartsorganisasjon IMO er enige om å sikte mot null utslipp i 2050. Men hvordan skal vi nå målet? Gjennom SFI Smart Maritime, har forskere fra SINTEF Ocean og NTNU, i samarbeid med maritim bransje...

MISSION, et nytt EU-prosjekt, vil utvikle og demonstrere tre nye SF6-frie bryteranleggskomponenter for mellom- og høyspenning (MV og HV).

I dag er det nemlig ikke lov å mate dyr med fôr som kommer fra egen “verdikjede”. Men loven er ikke basert på vitenskap.

Klimagassutslipp knyttet til VVS-installasjoner må beregnes og optimeres for å oppnå nasjonale og internasjonale klimamål, viser en forskningsrapport.

Gikk du glipp av SINTEFs byggskadedag? Nå kan du kjøpe tilgang til opptak av arrangemenet.

Forskning viser at brosme har stort potensiale som middagsfisk på norske matbord. Men skal du kjøpe den i dag, må du lete.

Solstormer er ingen spøk. Det kan bli kaldt. Det kan bli mørkt. Mobilnettet kan svikte.

Et nytt tareanlegg er etablert i Frohavet utenfor Frøya på Trøndelagskysten. Prosjektet startet i 2022, i sommer ble konsesjon gitt fra fylket og nå er de første kimplantene satt ut. Sjøanlegget skal blant annet brukes til å teste hvordan storskala...

Regjeringen avvikler de regionale forskningsfondene. Helt uforståelig for oss som har sett ordningen fungere som startmotor for grønn innovasjon og omstilling i mange små bedrifter.

Norge eksporterer allerede alginat for store beløp. Nye funn kan gjøre industrien enda større og mer bærekraftig.

Veilederen gir råd om analytisk brannteknisk prosjektering av trekonstruksjoner i bygg der preaksepterte ytelser i veiledningen til de norske byggereglene (TEK17) ikke kan benyttes.

Byggforskserien beskriver når det er behov for branncellebegrensende bygningsdeler mellom lave bygninger, og hvilke konstruksjoner som oppfyller kravene.

Nå kommer sprengkulden, også for dyrene. – Kle på hunden og slipp kattene inn, sier kuldeforsker Øystein Wiggen.